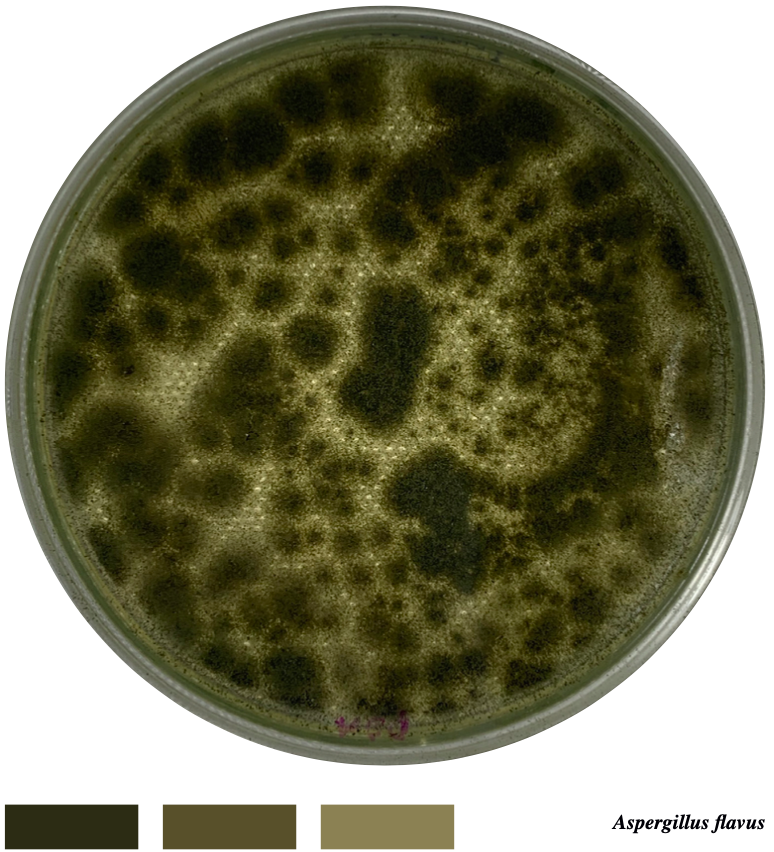
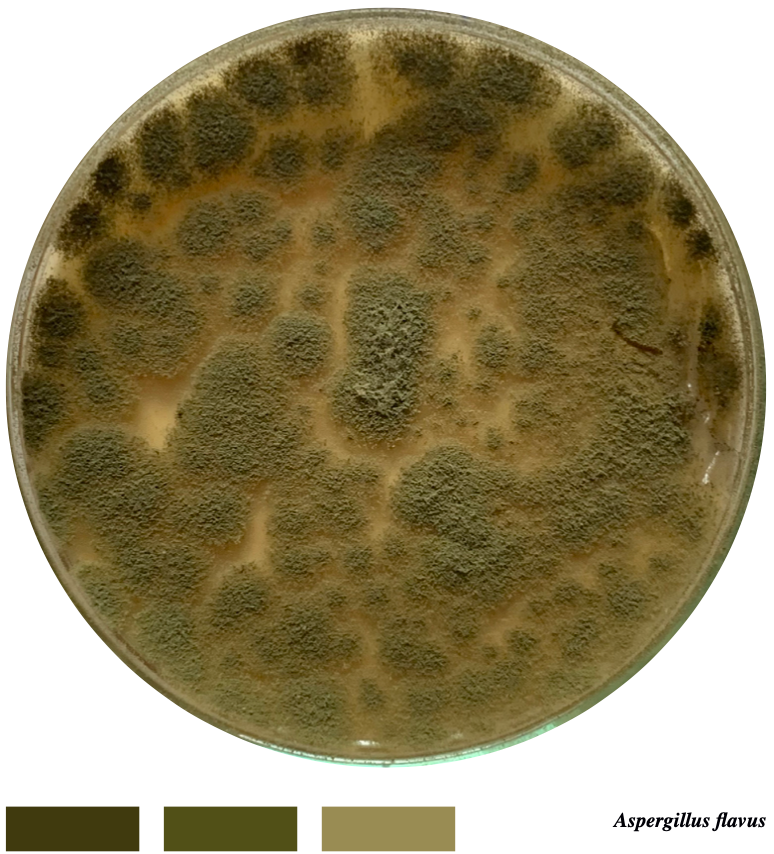

Fungarium es un proyecto que busca cambiar el cristal a través del cual las personas miran los hongos, para de esta manera sembrar una semilla de cambio que haga reflexionar sobre la maravilla del mundo de los hongos, y que pueda motivar a incentivar su exploración dentro de otros campos.
El proyecto se realiza con hongos filamentosos, pues estos se encuentran en el ambiente, superficies, comida y demás, y su variedad de colores y texturas permiten variedad de caminos a lo largo del desarrollo del proyecto.

Para comenzar con el desarrollo del proyecto, se crea un banco de hongos obtenidos en distintos ambientes, esto se logra dejando abierto un frasco con medio en el lugar o pasando un copo de algodón por la superficie y luego sembrando lo recogido en el medio.
El medio está elaborado con: agua con papa pastusa, azúcar y gelatina sin sabor.
De izquierda a derecha:
Ambiente de biblioteca, entre los dedos de un perro, ambiente de jardín, ambiente de una cascada, saliva de gato.


A lo largo de la investigación se encontró que las personas asocian a los hongos principalmente con tres palabras: Asco, Descomposición y Psicodelia. Sin embargo, lo hacen de manera negativa, viendo al hongo como un organismo peligroso, sucio y desagradable.
Pero, ¿qué pasaría si estas tres palabras representaran algo maravilloso en lugar de algo desagradable?


Se realizaron múltiples prototipos en distintos medios y con distintas especies para observar patrones y tiempos de crecimiento, así como las relaciones entre los colores y texturas de los distintos hongos. Cada uno crece a una velocidad diferente, por lo que de esta manera se pudo determinar en qué orden se plantarían los hongos y así evitar la sobre población dentro del medio.
Una vez se eligieron los hongos, la fabricación de las piezas finales se hizo con moldes transparentes (vidrio) para poder dejar ver la complejidad del organismo que crece en su interior. Los moldes que se utilizaron fueron de 30cm x 20 cm x 4 cm, pero el tamaño puede variar. La estructura también debía ser plana para no dar complejidad al trabajo de los hongos ni impedir su crecimiento. Con los moldes listos, se aplicó dentro el medio necesario para el crecimiento de los hongos, cada uno con diferente color dependiendo de la pieza deseada y de los hongos que se iban a plantar para resaltar sus características.


Moldes con medios a base de agar al interior.

Hongos elegidos para el desarrollo de las piezas finales.

Proceso de plantación de los hongos dentro del medio.
Las piezas finales corresponden a tres series de Fungarium: la serie Asco, la serie Descomposición y la serie Psicodelia. Cada una está ligada a su nombre a través sus colores, formas y texturas, sin embargo, se muestran como una paradoja convirtiendo las emociones que evocan estas palabras en tres piezas de arte. El fin del proyecto es generar un diálogo entre los organismos y los espectadores, y así convertir las perspectivas negativas que se tienen sobre los hongos en experiencias positivas.




Universidad de Los Andes (2020-02)
Estudio 8
Asesora de proyecto de grado:
Giovanna Danies